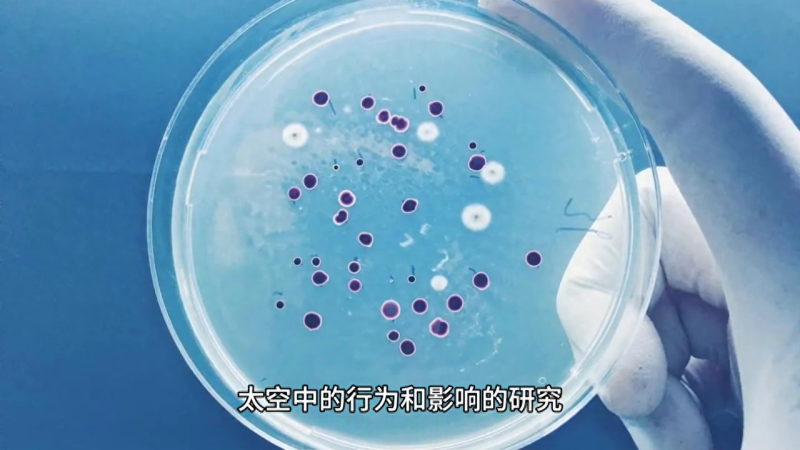

【宇宙探索】宇宙旅行的挑战与伦理问题
继续深入探讨宇宙探索,我们可以关注一些不同的方面和问题。宇宙旅行的挑战:长时间的太空旅行对宇航员的身体和心理健康提出了巨大挑战。研究如何解决这些挑战以确保太空探险的可行性是一个重要议题。宇宙中的微生物:宇宙探索也涉及对微生物在太空中的行为和影响的研究,了解它们如何生存和演化有助于我们应对太空环境中的生物学挑战。
太空中的军事应用:太空领域不仅有和平目标还涉及军事应用,国际社会需要制定规则和法律以确保太空的和平利用。社会影响和伦理问题:宇宙探索对社会产生深远影响,包括启发年轻人追求科学职业,创造工作机会和推动科技创新。同时它也带来了伦理问题,如太空资源分配和太空垃圾处理。
文化和艺术:宇宙探索不仅是科学和技术的领域,还为文化和艺术提供了灵感。宇宙题材的文学、电影和艺术作品一直是人类创作的重要部分。宇宙旅行的商业化:私人太空公司的兴起使宇宙旅行变得更加商业化,这为普通人提供了机会亲身体验太空探险。

宇宙探索是一个涉及多个领域的综合性课题,它引发了无数重大问题和机遇,从科学和技术到社会和伦理,宇宙探索影响着人类的各个层面,我们可以期待在未来它将继续激励人们去追求知识,探索未知并为人类的未来开辟新的可能性。
上一篇:探索宇宙的秘密
大家都在看
-
精妙绝伦的宇宙探索未解之谜 6个精妙绝伦的宇宙未解之谜,颠覆认知的星际谜题至今无解!宇宙浩瀚如穹顶,藏着无数超越想象的奥秘。从神秘的暗物质到诡异的黑洞奇点,从外星文明的猜想 to 宇宙的终极命运,这些未解之谜既牵动着科学家的探索神经 ... 宇宙探索12-03
-
用我们能读得懂的语言走进宇宙前沿知识——引力的了解和探索之中 在人类探索宇宙的漫长历史中,我们逐渐掌握了更多宇宙的秘密,宇宙的运行规则最终被归结为四种力,它们都非常神秘,难以理解,是宇宙探索的最前沿理论。而它们之中,引力与我们最为接近,也最容易被我们理解。它既是 ... 宇宙探索12-02
-
【标题】天文与宇宙探索带你走进神秘的星空世界,揭开宇宙的秘密 嘿,朋友们!你有没有想过,天上的那些星星到底藏着什么秘密?为什么我们能看到那么多星座?人类又是怎么一步步走进浩瀚宇宙的?今天就带你深入了解一下天文和宇宙探索的那些事,让你对星空有更酷、更震撼的认识!说 ... 宇宙探索12-02
-
70年后人类如何探索宇宙?中国科技馆“筑梦星球”展提供科幻答案 中新网北京12月1日电 (记者 孙自法)70年之后,人类会取得哪些重大科技突破?人们将如何进一步探索和利用宇宙空间?……中国科技馆最新推出的“筑梦星球”科幻主题展览,为这些问题准备了答案。最新推出的“筑梦星球 ... 宇宙探索12-02
-
从1912到2025,宇宙射线起源探索终突破,中国观测站功不可没 本文内容均是根据权威材料,结合个人观点撰写的原创内容,辛苦各位看官支持。2025年11月,四川稻城亚丁海拔4410米的高原上,LHAASO观测站的探测器突然记录到一串异常数据。这个由数千个闪烁体和水切伦科夫探测器组成 ... 宇宙探索11-30
-
无限与樊笼:论宇宙探索中的人类认知边界 文/星火燎原 在浩渺无垠的宇宙长河中,我们所在的银河系,是一个拥有数千亿颗恒星、横跨十万光年的宏伟天体系统。在其旋臂之上,我们的太阳、我们的地球,不过是这亿万分之一的微光。在人类有限的感知中,银河系的尺 ... 宇宙探索11-29
-
地球存在如此多威胁人类的问题,为什么还要投资探索宇宙呢? 当森林大火吞噬加州社区、气候变化威胁全球稳定、流行病挑战公共卫生体系时,质疑天文学研究价值的声音显得合情合理。毕竟,在2025年1月的加州山火中,损失超过2500亿美元,而美国林务局的年度预算却不足100亿美元。在这 ... 宇宙探索11-29
-
中国航天再破局!卫星天团探索宇宙,千年谜题即将揭晓 哈喽大家好,今天小无带大家聊聊最近全网沸腾的航天大动作!2025年11月24日下午,北京怀柔科学城一场发布会直接把全网炸翻了!没有流量明星,没有花边新闻,就靠一个十五五太空探源科学卫星计划,网友们的留言直接刷 ... 宇宙探索11-28
-
中国“太空天团”将出征!四颗卫星开启宇宙终极探索之旅 当你仰望星空,是否好奇宇宙如何诞生、地球是否孤独、黑洞真面目究竟是什么?我国“十五五”期间(2026-2030)将发射四颗卫星,直击这些人类的终极疑问。在宇宙探索的征程上,中国正迈出震撼一步。“鸿蒙计划”卫星 ... 宇宙探索11-27
-
宇宙有多大:探索无垠星海的奥秘 在我们仰望星空的那一刻,常常会被浩瀚的宇宙所震撼。无数的星星闪烁着微弱的光芒,似乎在诉说着古老而神秘的故事。然而,宇宙的真正规模和奥秘,却远远超出了我们的想象。本文将带你走进宇宙的浩瀚,探索它的大小、 ... 宇宙探索11-24
相关文章
- 太空科技强国:探索宇宙的未来之路
- 空间站:人类探索宇宙的新前沿
- 利多星智投:从大气层内到宇宙深空的探索——航空航天入门指南
- 实践三十号卫星的成功发谢,为人类探索宇宙奠定了基础
- 探索宇宙的奥秘::从地球到星际的奇幻旅程
- 火星变“地球2.0”要多久?为什么比想象中更难一万倍?
- 人类文明仅1秒,凭什么敢探索138亿年的宇宙?
- 浑天仪:凝聚古人探索宇宙的智慧(字载匠心·惊艳时光的中国智慧)
- 从一束激光到量子奇迹:普通人也能看懂的纠缠实验全解读
- 人类是怎么用望远镜探索宇宙的?背后的原理到底是啥?
- 全国仅十几所!这 5 所天文学强校含金量拉满,探索宇宙就选它们
- 国内天文学三强高校深度解析:A + 学科背后的宇宙探索密码
- 宇宙探索:从火箭到火星的太空旅
- “多维宇宙探索”启幕,2025上海城市空间艺术季浦东分展区点亮张江
- 11部史诗级星际电影:探索宇宙的不同视角你看过几部?
- 探索“多维宇宙”,2025上海城市空间艺术季浦东分展区点亮张江
- 光速飞行未必能逃离银河,人类探索宇宙有多艰难?
- 中微子实验国际合作增进认知 或助力探索宇宙正反物质不对称
- 探索宇宙,亚毫米波不应成为“盲点”
- 你所看到的宇宙,或许只是幻影?全息宇宙理论颠覆认知!
热门阅读
-
预言2030年太阳将休眠,恐怖的千年极寒将来临 07-11
-
中国十大元帅之死,多高寿而善终(林彪叛逃而死) 07-11
-
因果报应真实事例,做尽坏事必遭天谴 07-11
-
全球人口减少可能带来的六大教训和好处 07-18
-
离太阳最近的十大恒星排名,宇宙最大十大星球 04-12
